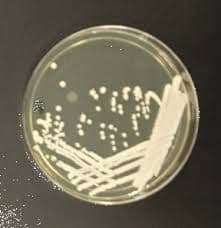
Yeast Extract Peptone Dextrose Mediums Market Report 2028

Yeast Extract Peptone Dextrose Mediums Market Report 2028
COVID-19 Impact Analysis on Yeast Extract Peptone Dextrose Mediums Market report published by Value Market Research provides a detailed market analysis comprising market size, share, value, growth and trends for the period 2020-2028. The report encompasses data regarding market share and recent developments by key players. Moreover, this market report also covers regional and country markets in detail.
The research report also covers the comprehensive profiles of the key players in the market and an in-depth view of the competitive landscape worldwide. The major players in the yeast extract peptone dextrose mediums market include Thermo Fisher Scientific, Hardy Diagnostics, SRI International, Himedialabs, Tulip Diagnostics Private Limited, Microxpress, Scharlab, HiMedia Laboratories, Cyrusbioscience. This section consists of a holistic view of the competitive landscape that includes various strategic developments such as key mergers & acquisitions, future capacities, partnerships, financial overviews, collaborations, new product developments, new product launches, and other developments.
Get more information on "Global Yeast Extract Peptone Dextrose Mediums Market Research Report" by requesting FREE Sample Copy at https://www.valuemarketresearch.com/contact/yeast-extract-peptone-dextrose-mediums-market/download-sample
Market Dynamics
Expanding research & development activities in genome, biofuel, and microbiology is anticipated to spur demand for yeast extract peptone dextrose medium. In the laboratory study, the preparation of sterile media of consistently high quality is essential for yeast's genetic manipulation. Treatment with YEPD mediums provides a highly efficient and cost-saving method for the production of yeast. However, it is a non-selective medium and cannot be used as a selection medium to test for auxotrophs that restrict the market growth.
The research report covers Porter’s Five Forces Model, Market Attractiveness Analysis, and Value Chain analysis. These tools help to get a clear picture of the industry’s structure and evaluate the competition attractiveness at a global level. Additionally, these tools also give an inclusive assessment of each segment in the global market of yeast extract peptone dextrose mediums. The growth and trends of yeast extract peptone dextrose mediums industry provide a holistic approach to this study.
Browse Global Yeast Extract Peptone Dextrose Mediums Market Research Report with detailed TOC at https://www.valuemarketresearch.com/report/yeast-extract-peptone-dextrose-mediums-market
Market Segmentation
This section of the yeast extract peptone dextrose mediums market report provides detailed data on the segments at country and regional level, thereby assisting the strategist in identifying the target demographics for the respective product or services with the upcoming opportunities.
By Type
Liquid
Solid
By Application
Biology
Laboratory
Regional Analysis
This section covers the regional outlook, which accentuates current and future demand for the Yeast Extract Peptone Dextrose Mediums market across North America, Europe, Asia-Pacific, Latin America, and Middle East & Africa. Further, the report focuses on demand, estimation, and forecast for individual application segments across all the prominent regions.
Purchase Complete Global Yeast Extract Peptone Dextrose Mediums Market Research Report at https://www.valuemarketresearch.com/contact/yeast-extract-peptone-dextrose-mediums-market/buy-now
About Us:
Value Market Research was established with the vision to ease decision making and empower the strategists by providing them with holistic market information.
We facilitate clients with syndicate research reports and customized research reports on 25+ industries with global as well as regional coverage.
Contact:
Value Market Research
401/402, TFM, Nagras Road, Aundh, Pune-7.
Maharashtra, INDIA.
Tel: +1-888-294-1147
Email: sales@valuemarketresearch.com
Website: https://www.valuemarketresearch.com
Appreciate the creator